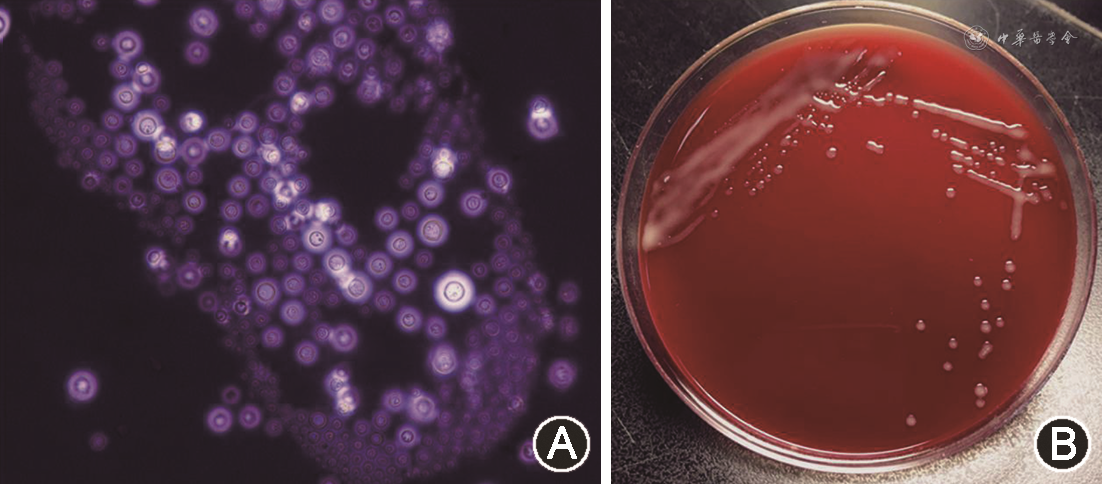

隐球菌性脑膜炎是由隐球菌侵犯脑膜和(或)脑实质所导致的中枢神经系统感染,以严重的颅内压增高、脑实质损害为特征,起病隐匿。这种机会性感染常见于人类免疫缺陷病毒(HIV)感染者、器官移植受者或其他免疫抑制情况,也见于少部分免疫功能正常人群。在全球HIV感染逐年减少的背景下,隐球菌性脑膜炎仍然有较高的发病率,且病死率居高不下。文中重点对隐球菌性脑膜炎的易患人群、临床表现、影像学特点、诊断方法及治疗方案进行介绍。
版权归中华医学会所有。
未经授权,不得转载、摘编本刊文章,不得使用本刊的版式设计。
除非特别声明,本刊刊出的所有文章不代表中华医学会和本刊编委会的观点。
经全国继续医学教育委员会批准,本刊开设继教专栏,2022年从第3期开始共刊发10篇继教文章,文后附5道单选题,读者阅读后可扫描标签二维码答题,每篇可免费获得Ⅱ类继教学分0.5分,全年最多可获5分。本年度继教答题得学分活动于10月31日结束。
隐球菌性脑膜炎(cryptococcal meningitis)是最常见的真菌性中枢神经系统感染,也是隐球菌病最常见的表现。绝大多数隐球菌性脑膜炎的病原菌为新型隐球菌和格特隐球菌,其中格特隐球菌有明显的地域性,在我国少见。在此,我们仅探讨新型隐球菌相关感染。新型隐球菌有很强的侵袭性,几乎总是累及脑实质,可导致脑膜炎、脑膜脑炎、脑脓肿或脑和脑膜的肉芽肿等,病死率和致残率均很高,造成严重的疾病负担[1]。近年来隐球菌性脑膜炎的治疗进展十分有限,治疗仍依赖于3种主要药物,主要的诊治参考依然为2010年发布的《隐球菌病治疗临床实践指南:美国感染病学会2010更新》[2]。我国则在2018年根据国内的临床实践,制订了《隐球菌性脑膜炎诊治专家共识》[3]。如何利用有限的资源及有限的药物优化治疗方案是目前研究的重点。
隐球菌病是一种机会性感染。隐球菌的病原体常见于鸽子的巢穴和粪便中,通过呼吸进入肺部。在免疫正常的宿主中,吸入的隐球菌会被有效地清除,但是在免疫功能低下的个体中,隐球菌可以增殖并播散到中枢神经系统,从而跨越血脑屏障,导致脑膜脑炎。
隐球菌病高发于3类人群:人类免疫缺陷病毒(HIV)感染者、器官移植受者、非HIV感染和非移植宿主[2]。在全球范围内,CD4+T细胞计数<100个/μl的HIV感染者隐球菌抗原阳性检出率平均为6.0%,90%的隐球菌脑膜脑炎病例见于该人群[4]。近年,随着高效抗逆转录病毒治疗(HAART)的广泛普及,HIV相关的病例发病率一直在下降,但病死率并未下降[4, 5, 6]。根据2014年的报告,估计全球每年新发22.3万例病例,造成每年18.1万例死亡[4]。
对于器官移植受者,隐球菌感染见于平均2.8%的患者,其中52%~61%的隐球菌感染患者有中枢神经受累和播散性感染[7, 8, 9]。其他非HIV感染者相关隐球菌性脑膜炎患者,多数存在各种原因导致的免疫抑制,包括:糖皮质激素治疗、恶性肿瘤、自身免疫性疾病、糖尿病、终末期肾功能衰竭及肝硬化等[10]。另有研究数据显示7%~32%的隐球菌性脑膜炎患者免疫功能正常[3],但这些所谓“免疫功能正常”的患者可能存在原发性免疫缺陷或罕见的自身免疫疾病,例如特发性CD4+淋巴细胞减少症、抗干扰素-γ的自身抗体疾病等[11]。
在中国人群,84%的隐球菌性脑膜炎与HIV感染无关,而且25%~68%的感染发生在免疫功能正常的个体,以华人为主要民族的其他亚洲国家的研究也报道了类似结果(81%~96%的患者免疫功能正常)[12]。这种独特的现象可能是由于中国汉族人群中甘露聚糖结合凝集素基因和Fc-γ受体2B基因多态性所致[12]。
来自美国和法国的研究结果表明,尽管使用HAART,HIV感染者10周病死率为15%~26%[13, 14, 15]。与之相比,非HIV感染者病死率并不低,90 d病死率为27%[16]。HIV相关隐球菌性脑膜炎和非HIV相关隐球菌性脑膜炎的病死率在1年时分别达78%和42%[1]。
隐球菌性脑膜炎的临床表现多样,不具有特异性。
隐球菌性脑膜炎大部分呈慢性病程,起病隐匿,表现为亚急性或慢性脑膜炎的症状或体征,在诊断前症状可长达数月,也可在数日内暴发起病。HIV感染者一般感染隐球菌后2周左右出现症状,非HIV感染者则在6~12周后出现症状[11]。
患者常表现为进展性头痛、低热,少数可不发热或达40 ℃。顽固颅内压增高是突出表现,引起剧烈恶心、呕吐、视乳头水肿及出血、视力减退、意识障碍等。当出现颅底粘连可引起脑神经麻痹(复视、面瘫、听觉异常、视力障碍等)。当隐球菌进入脑实质,可形成脑脓肿或肉芽肿,可出现意识障碍、癫痫发作、精神症状、偏瘫等症状。
1.细胞学及生化常规检测:隐球菌性脑膜炎患者脑脊液外观通常清晰透明,如果有大量隐球菌,则可能轻微浑浊。白细胞计数通常<500×106/L,多为(10~15)×106/L,且以单个核细胞为主。常见蛋白轻微升高(0.5~1.0 g/L)及葡萄糖水平偏低(2.0~2.5 mmol/L),葡萄糖降低程度较结核性脑膜炎、化脓性脑膜炎轻。10%~17%的患者脑脊液检查正常,尤其是HIV患者[18, 19]。脑脊液常规结果正常,不能排除隐球菌性脑膜炎。
2.印度墨汁染色涂片:墨汁染色涂片诊断隐球菌性脑膜炎的敏感度较低,约75%的HIV感染者及50%的非HIV感染者可出现阳性结果[20, 21]。当真菌负荷<1 000菌落形成单位/ml时,其敏感度仅为42%,容易漏诊[22]。详见图1A。

3.隐球菌培养:隐球菌培养被认为是诊断隐球菌性脑膜炎的“金标准”,>90%的患者培养呈阳性,当真菌负荷较低时也可能出现假阴性。在实验室,通常3~7 d才可以看到隐球菌生长,若经抗真菌治疗,最迟可在第3周开始生长[3]。用于培养的脑脊液至少为3~5 ml,取15 ml以上脑脊液可以提高检出率。虽然培养时效性不足,不过定量培养可以计算真菌负荷及真菌清除率,可用于预测预后并监测治疗反应[23]。具体见图1B。
4.隐球菌荚膜抗原(CrAg)检测:检测方法有乳胶凝集试验(latex agglutination test,LA)、酶联免疫分析法(enzyme immunoassay,EIA)及侧流免疫层析法(lateral flow assay,LFA)等。LA和EIA检测脑脊液CrAg的敏感度达93%~100%,特异度达93%~98%[24]。LFA最常使用胶体金做标记,是一种快速、低成本诊断方法,用于定量或定性检测复杂混合物中的分析物,在5~30 min内提供结果,大大缩短了疾病的诊断时间,目前已经成为全世界检测CrAg的主要办法。LFA检测脑脊液CrAg的敏感度和特异度均达99%以上[25],可以作为确诊的依据。抗原滴度的高低通常与真菌负荷相关,但不能根据滴度监测治疗反应,因为隐球菌菌体死亡后仍会持续释放抗原,即使多次培养转阴后,抗原仍可被检测出[3]。
对于非脑脊液的体液,LA、EIA检测CrAg的敏感度远远低于LFA,尤其是对于非HIV病例。在HIV感染者中,LFA检测血清CrAg的敏感度为100%,而在非HIV感染者中,敏感度为82.6%[26]。应用LFA,可以在HIV感染者出现症状前6~7个月即可检测出血液中的CrAg,基于血清CrAg的筛查和抗真菌治疗可将启动HAART的晚期HIV患者的病死率降低28%[27, 28]。
隐球菌性脑膜炎的影像学表现包括:软脑膜和硬脑膜强化、扩张的血管周围间隙、胶状假性囊肿、隐球菌瘤、肉芽肿、脑积水、脑萎缩、血管炎等,但仅有21%~27%的病例在MRI上有典型的隐球菌性脑膜炎影像学表现(图2)[29]。影像学表现受患者免疫状态和治疗反应的影响,免疫功能低下者,炎性反应较轻或不存在,影像学可无特殊表现,当通过抗真菌和HAART治疗,患者免疫力得到恢复,机体出现炎性反应以限制感染,形成脓肿或肉芽肿。因此,胶状假性囊肿、隐球菌瘤或脑膜强化等在免疫功能低下者中相对少见,而更多见于免疫功能正常的患者[30]。


隐球菌性脑膜炎的临床表现、脑脊液改变及影像学均缺乏特异性。当临床遇到存在头痛、发热、颈项强直等脑膜炎表现同时合并以下情况,无论患者是否存在免疫功能缺陷,都需特别注意隐球菌感染的可能:(1)存在神经功能缺损的相关症状或体征;(2)腰椎穿刺提示显著颅内压增高或眼底照相提示急性或慢性视乳头水肿;(3)影像学显示交通性脑积水或有颅内占位病变;(4)临床拟诊为结核性脑膜炎,但规范抗结核治疗效果不佳。
隐球菌性脑膜炎的确诊依赖于脑脊液微生物鉴定及免疫学检查。脑脊液墨汁染色或培养阳性均可确诊隐球菌感染,但微生物鉴定的敏感度低,且耗时较长。推荐LFA检测脑脊液CrAg作为快速诊断的主要依据,避免延误治疗。后续根据培养结果来判断治疗反应及疗程。
隐球菌性脑膜炎患者往往需要长期使用抗真菌治疗,最佳的治疗方案包括完整的诱导、巩固和维持3个阶段[2]。常用药物包括:静脉用两性霉素B的各种剂型(两性霉素B去氧胆酸盐、两性霉素B脂质制剂等,下文中的两性霉素B均指代两性霉素B去氧胆酸盐,其他剂型会单独说明)、氟胞嘧啶口服制剂、唑类药物的静脉或口服制剂(氟康唑、伏立康唑、伊曲康唑等)。两性霉素B杀菌活性强,氟康唑则仅有抑菌作用。氟胞嘧啶为抑菌药,高浓度时具有杀菌活性,不过隐球菌对氟胞嘧啶原发性和(或)获得性耐药的发生率较高,因此需要与其他抗真菌药物合用[31]。
各阶段的治疗方案通常为上述药物的单药或多药联合,药物选择受药物可获得性、经济状况、药物不良反应、药物相互作用、依从性等各因素的限制。目前隐球菌性脑膜炎治疗的经验大部分来自HIV感染相关病例,非HIV感染者的抗真菌治疗方案基本与HIV感染者相同(表1)。

隐球菌性脑膜炎抗真菌治疗的常用药物
Common antifungal regimens for cryptococcal meningoencephalitis
隐球菌性脑膜炎抗真菌治疗的常用药物
Common antifungal regimens for cryptococcal meningoencephalitis
| 诱导期a | 巩固期 | 维持期 |
|---|---|---|
| 两性霉素Bb+氟胞嘧啶c+氟康唑d | 氟康唑 400~800 mg/d口服(8周) | 氟康唑200~400 mg/d 口服(HIV患者:≥12个月;非HIV患者:6~12个月) |
| 两性霉素Bb+氟胞嘧啶c | ||
| 氟胞嘧啶c+氟康唑d | ||
| 两性霉素Bb+氟康唑d | ||
| 两性霉素Bb | ||
| 氟康唑 1 200 mg/d口服(10~12周) |
注:a若两性霉素B不耐受或本身为器官移植受者,建议使用两性霉素B脂质制剂(两性霉素B脂质体 3~4 mg·kg-1·d-1 静脉注射 1次/d,两性霉素B脂质复合物 5 mg·kg-1·d-1 静脉注射1次/d);b两性霉素B:0.7~1.0 mg·kg-1·d-1静脉注射 1次/d;c氟胞嘧啶:25 mg·kg-1·d-1 口服 4次/d;d氟康唑 800~1 200 mg/d 口服;HIV:人类免疫缺陷病毒
1.诱导期:诱导期快速清除大部分隐球菌是治疗成功的关键,因为脑脊液真菌负荷下降速率与病死率、复发率密切相关[27]。目前公认最佳的诱导期方案为两性霉素B联合氟胞嘧啶,该组合有协同作用,灭菌活性最强,且不增加药物毒性,与其他方案(表1)相比可大幅降低病死率[27,32, 33, 34, 35, 36]。当没有氟胞嘧啶时,推荐两性霉素B和氟康唑联合使用,优于两性霉素B或氟康唑单用。两性霉素B脂质制剂的肾毒性、输液反应(发热、静脉炎等)、贫血等不良反应更少,且与钙调磷酸酶抑制剂(环孢素A、他克莫司等)联用不增加肾毒性,对两性霉素B不耐受或者器官移植受者可作为首选。
诱导期疗程:诱导治疗的疗程取决于选用的方案、是否有HIV感染、症状的严重程度及对治疗的反应、是否伴有隐球菌瘤以及脑脊液培养结果等。理想情况下诱导疗程应根据每2周的脑脊液培养结果,直到培养阴性时才过渡为巩固治疗。不过经抗真菌治疗后的脑脊液培养可能需要2~3周才出结果,难以及时确定疗程。过长的诱导期则可能因药物毒副作用抵消诱导期快速杀菌的获益。既往研究多在资源受限区域,通过腰椎穿刺确定脑脊液灭菌的比例较低,往往根据不同人群选择固定时长的诱导及巩固疗程来实施治疗。应用两性霉素B+氟胞嘧啶的标准治疗,60%~90%的HIV感染者在2周时脑脊液培养转为阴性[20,37],52.3%的器官移植受者在2周时脑脊液培养转为阴性[38],针对这两类人群,指南推荐至少2周的诱导治疗[2]。非HIV感染且非移植受者症状往往较重,指南推荐至少4周的诱导治疗,如果存在神经系统并发症(持续性头痛、癫痫发作、眼部及听觉异常表现等)或隐球菌瘤,则推荐诱导治疗持续至少6周[2]。如果选用其他方案,则需要适当延长治疗时间,如:针对HIV感染者,两性霉素B单药推荐4~6周疗程;氟康唑单药推荐10~12周疗程。
短程诱导疗法可以降低药物的不良反应。非洲隐球菌性脑膜炎的抗真菌联合治疗研究在HIV感染者中尝试1周的短程诱导疗法(两性霉素B 0.7~1.0 mg·kg-1·d-1+氟胞嘧啶100 mg·kg-1·d-1),相比标准的2周疗法,两种方案有相似的真菌清除率,而且10周病死率更低,不良反应的发生率更低[34],该结论得到2018年一项荟萃分析的支持[39]。世界卫生组织(WHO)2018年隐球菌性脑膜炎的管理指南对HIV感染者,推荐第1周(两性霉素B+氟胞嘧啶)、第2周(氟康唑 1 200 mg/d)的诱导方案[40]。
利用两性霉素B脂质体的相对安全性及脑组织中的长半衰期,另一种降低药物不良反应的方案为单剂高剂量两性霉素B脂质体(10 mg/kg),序贯14 d的氟康唑1 200 mg/d和氟胞嘧啶100 mg·kg-1·d-1。两性霉素B脂质体诱导疗法优化(AMBITION)Ⅱ期临床研究结果提示,单次高剂量两性霉素B脂质体的方案,无论是早期杀菌活性还是耐受性均与标准疗法相当[41]。基于该研究结果,目前正在开展AMBITION Ⅲ期临床研究,比较该单次高剂量诱导方案与上述WHO推荐的短程诱导方案的安全性及疗效[42]。
2.巩固期:巩固期治疗的目标是脑脊液隐球菌培养转阴性。首选氟康唑,其药物相互作用及胃肠道毒性少,耐受性良好[33]。药物的剂量及疗程与诱导期的方案及疗效密切相关,若诱导期为两性霉素B+氟胞嘧啶,则巩固期推荐低剂量氟康唑(400 mg/d至少8周);若诱导期为两性霉素B+氟康唑,则推荐高剂量氟康唑(800 mg/d至少8周)。若诱导治疗后症状缓解,脑脊液培养阴性,则可选择低剂量方案;若疗效不明确,对于诱导治疗失败风险较高者,则可继续诱导治疗或选择高剂量方案。
3.维持期:维持治疗的目的主要是避免复发。首选氟康唑200 mg/d,HIV感染者需要至少12个月疗程,非HIV感染者需要6~12个月疗程。长期服用高剂量免疫抑制剂者、存在隐球菌瘤者可能需要延长治疗。巩固和维持治疗后的复发率极低。HIV感染者未经维持治疗的复发率为15%~27%,完成维持治疗的复发率为0~7%[43]。器官移植受者完成6~12个月维持治疗,复发风险为1.3%[38]。
4.治疗监测:两性霉素B常导致肌酐升高、贫血、肾小管酸中毒、低钾血症等,联用氟胞嘧啶可能增加肾毒性。氟胞嘧啶还可导致白细胞减少或血小板减少,建议治疗过程中监测血药浓度。氟康唑常导致转氨酶升高。在抗真菌治疗期间,需密切监测血常规、肝肾功能、电解质等变化,评估药物耐受性,及时调整方案。
对隐球菌性脑膜炎使用糖皮质激素辅助治疗的效果目前仍存在争议。在非HIV感染者中,糖皮质激素可能降低颅内压、减轻占位效应和灶周水肿或改善神经后遗症[44]。相比之下,糖皮质激素作为HIV感染者抗真菌治疗的辅助手段可能是有害的,使用激素者脑脊液肿瘤坏死因子-α水平下降,隐球菌从脑脊液中清除速度减慢,感染、肾脏或心脏事件等不良反应增加,病死率增加[45, 46]。目前对糖皮质激素的具体应用方式缺乏共识,通常用于诱导期,与抗真菌治疗同时应用,我们常应用地塞米松10~15 mg/d,2周后根据临床表现逐渐减量,于巩固期及维持期停用。
60%~80%的隐球菌性脑膜炎患者颅内压在250 mmH2O(1 mmH2O=0.009 8 kPa)以上,25%的患者颅内压>350 mmH2O[31,47]。严重的颅内压增高是隐球菌性脑膜炎患者早期死亡的重要原因,有效控制颅内压,可以改善临床症状,并为抗真菌治疗争取足够时间。因此,控制颅内压是决定隐球菌脑膜脑炎结局的最关键因素之一[20,31,48]。
药物治疗,包括甘露醇、高渗盐水等高渗疗法均可有效短暂降低颅内压。常用20%甘露醇125~250 ml或高张盐水(3%盐水150 ml、10%盐水50 ml等),每4~8小时团注1次维持治疗。渗透疗法可能会导致急性肾功能不全及电解质紊乱,治疗期间需密切监测患者出入水量、肾功能、电解质。当出现肌酐>120 μmol/L并持续升高时,建议停用甘露醇;当血钠>155 mmol/L时,建议停用高张盐水。当出现急性颅高压发作(表现为突发意识丧失、瞳孔散大、去大脑强制发作、Cushing反应等)时,使用甘露醇250~500 ml加压注射可快速降低颅内压,为脑脊液引流降压争取时间。
如果压力≥250 mmH2O或颅压增高症状一直存在,建议进行脑脊液引流,目标是将颅内压降至200 mmH2O以下或压力降低50%(若压力极高)[2]。在没有阻塞性脑积水或脑疝风险的情况下,每日连续腰椎穿刺可以缓解高颅压,每次最多引流脑脊液20~30 ml。对于不能耐受反复腰椎穿刺的患者,应考虑腰大池引流或侧脑室引流作为过渡性治疗,引流速度以5~10 ml/h为宜,每日引流150~300 ml。在有效抗真菌治疗的前提下,也可以考虑脑室腹腔分流术。
对于隐球菌性脑膜炎的诊断和治疗,目前在临床上仍面临诸多困难。尤其对于中国人群,绝大部分的患者与HIV感染无关,从HARRT中获益很少,需要优化管理方案。通过LFA检测CrAg可缩短隐球菌性脑膜炎的确诊时间并提高诊断正确率,同时应在治疗过程中通过脑脊液培养来监测治疗反应。两性霉素B、氟胞嘧啶、唑类药物是治疗隐球菌性脑膜炎的主要药物,严格完成诱导、巩固和维持3个治疗阶段,同时采取合适的措施控制患者颅内压,是成功治疗隐球菌性脑膜炎的关键。在此基础上,临床目前正在探索各种优化的诱导疗法,以期降低药物不良反应,进一步提高治疗的成功率。
所有作者声明不存在利益冲突
None declared
1. 在中国或以华人为主要民族的国家中,隐球菌性脑膜炎最常见于哪个人群?
A. HIV感染者
B. 器官移植受者
C. 肿瘤患者
D. 免疫功能正常者
2. 以下不能用于确诊隐球菌性脑膜炎的指标为?
A. 墨汁染色阳性
B. 脑脊液培养阳性
C. 血清隐球菌荚膜抗原阳性
D. 脑脊液隐球菌荚膜抗原阳性
3. 以下不属于隐球菌性脑膜炎的影像学特点的是?
A. 胶状假性囊肿
B. 隐球菌瘤
C. 同心圆样强化
D. 脑积水
4. 以下哪类抗真菌药物不用于治疗隐球菌性脑膜炎?
A. 棘白霉素类
B. 多烯类
C. 三唑类
D. 氟胞嘧啶
5. 治疗隐球菌性脑膜炎的3个阶段,不包括?
A. 诱导期
B. 加量期
C. 巩固期
D. 维持期





















